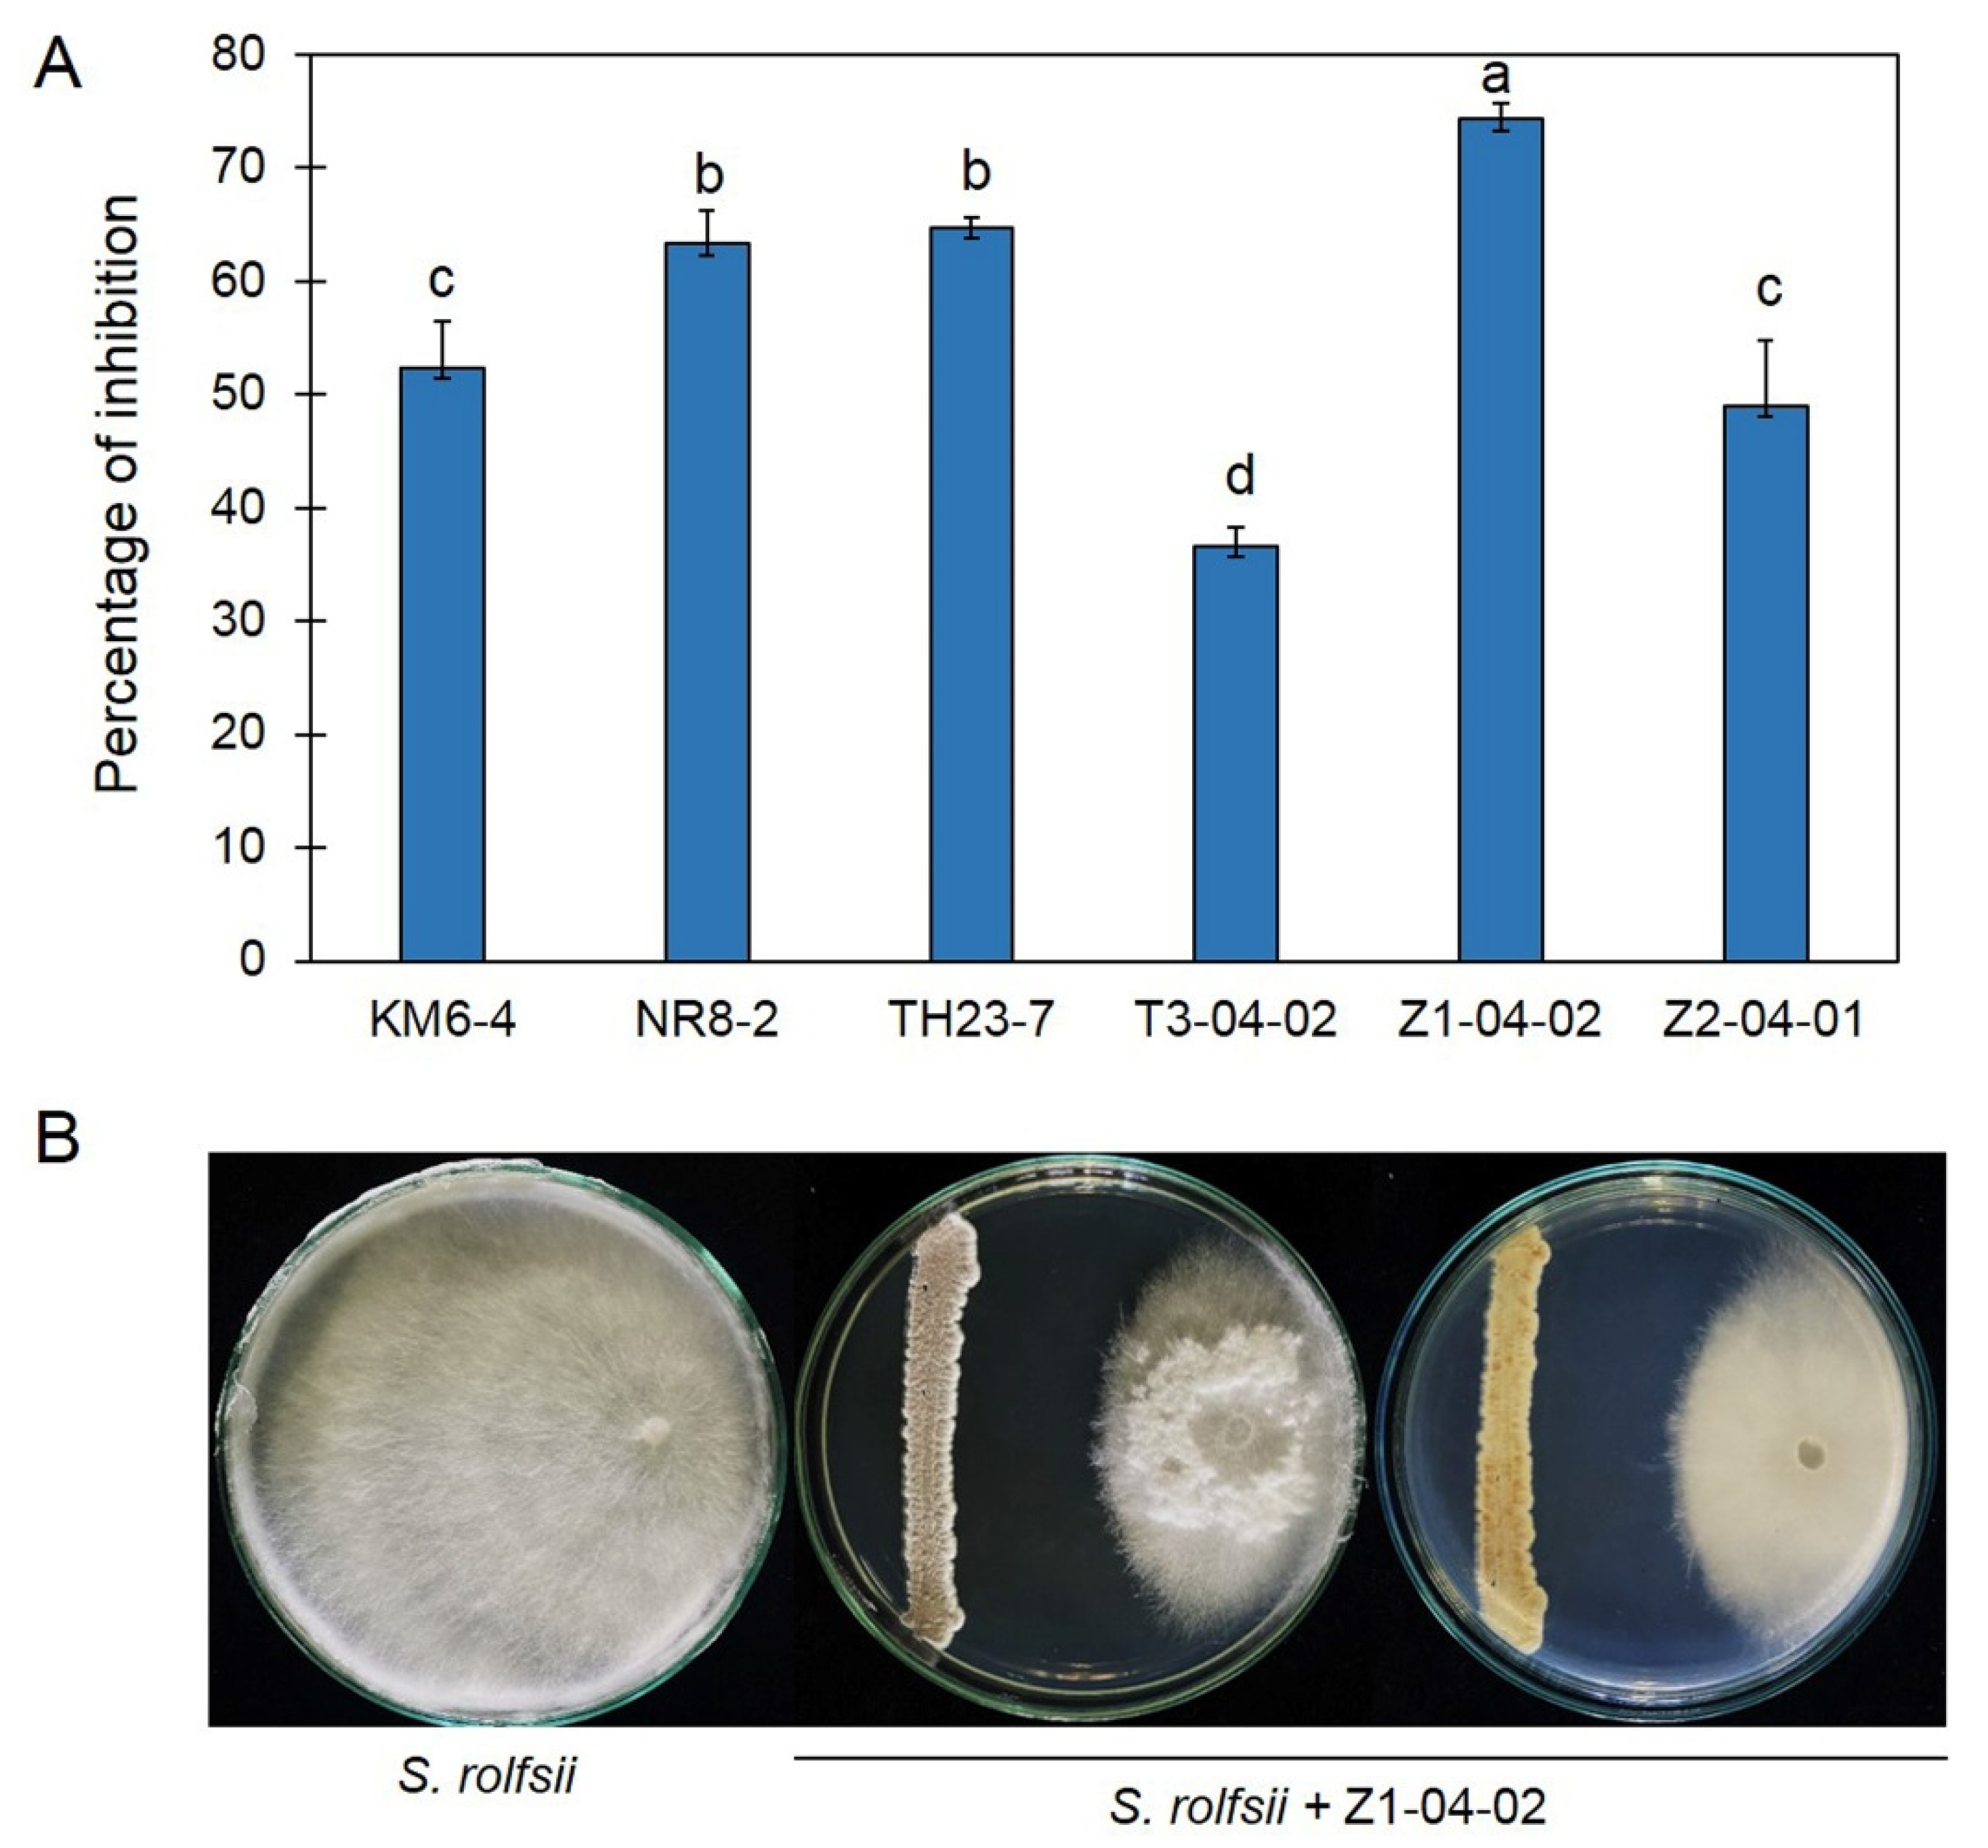
Plants 11 02607 g001 Plants 11 02607 g001
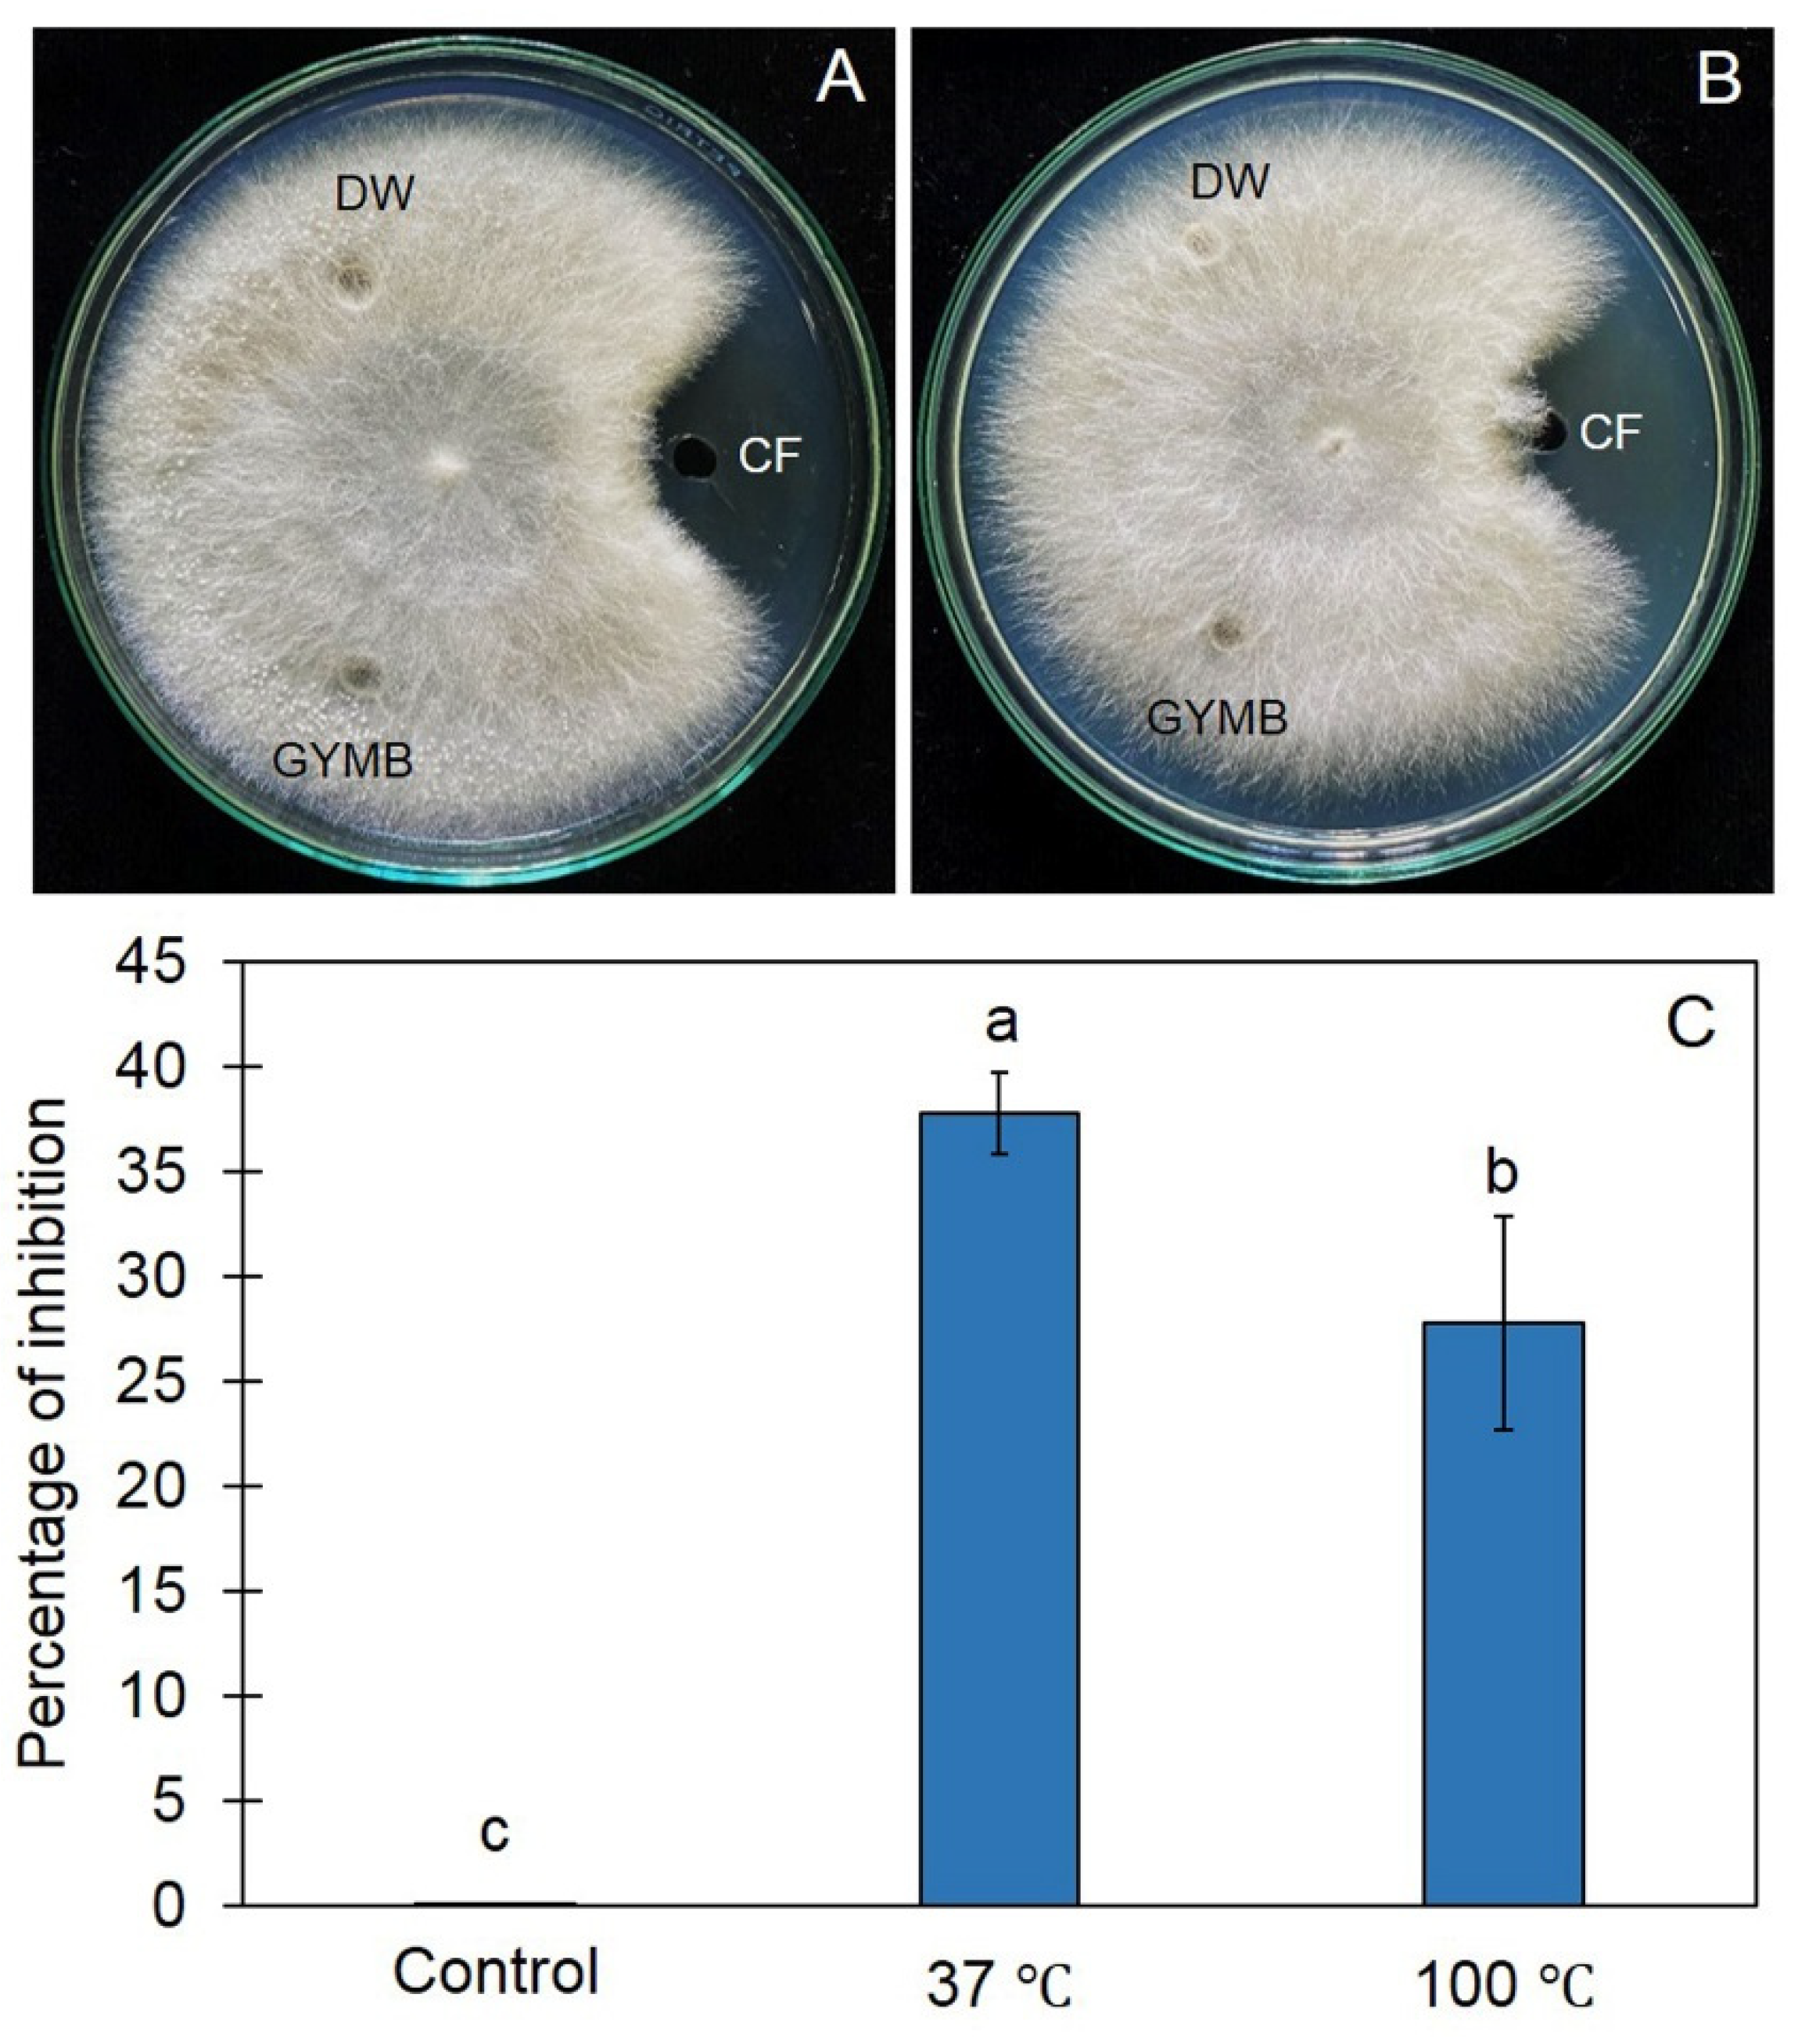
Plants 11 02607 g003 Plants 11 02607 g003

A Rhizobacterium, Streptomyces albulus Z1-04-02, Displays Antifungal Activity against Sclerotium Rot in Mungbean
Abstract
1. Introduction
2. Results
2.1. Antifungal Ability of Streptomyces against Sclerotium rolfsii
2.2. Cell Wall Degrading Enzyme Activities of Z1-04-02 Cell-Free CF
2.3. Cell-Free CF of Z1-04-02 Inhibited Growth of Sclerotium rolfsii
2.4. GC/MS Profiling of Volatiles Emitted by Z1-04-02
2.5. Sclerotium Rot Disease Suppression
2.6. Identification of Z1-04-02
3. Discussion
4. Materials and Methods
4.1. Sources of Actinobacteria and Pathogen
4.2. Dual Culture Assay
4.3. Bacterial Cultivation and Enzyme Assay
4.4. Agar Well Diffusion
4.5. Solid-Phase Microextraction–Gas Chromatography–Mass Spectrometry (SPME-GC/MS)
4.6. In Planta Test
4.7. Biochemistry Test and Identification of Actinobacterium
4.8. Statistical Analysis
5. Conclusions
Author Contributions
Funding
Data Availability Statement
Acknowledgments
Conflicts of Interest
References
- Kinkel, L.L.; Schlatter, D.C.; Bakker, M.G.; Arenz, B.E. Streptomyces competition and co-evolution in relation to plant disease suppression. Res. Microbiol. 2012, 163, 490–499. [Google Scholar] [CrossRef] [PubMed]
- Suárez-Moreno, Z.R.; Vinchira-Villarraga, D.M.; Vergara-Morales, D.I.; Castellanos, L.; Ramos, F.A.; Guarnaccia, C.; Degrassi, G.; Venturi, V.; Moreno-Sarmiento, N. Plant-growth promotion and biocontrol properties of three Streptomyces spp. isolates to control bacterial rice pathogens. Front. Microbiol. 2019, 10, 290. [Google Scholar] [CrossRef] [PubMed]
- Phoka, M.; Pornsuriya, C.; Sunpapao, A. High-throughput sequencing provides insight into soil fungal community structure and diversity in plant protected areas of Songkhla zoo in southern Thailand. Chiang Mai J. Sci. 2022, 49, 524–537. [Google Scholar] [CrossRef]
- Kämpfer, P. The family Streptomycetaceae—Part 1: Taxonomy. In The Prokaryotes, Bacteria: Firmicutes, Actinomycetes; Dworkin, M., Falkow, S., Rosenberg, E., Schleifer, K.H., Stackebrandt, E., Eds.; Springer: New York, NY, USA, 2006; Volume 3, pp. 538–604. [Google Scholar]
- Liu, D.; Anderson, N.A.; Kinkel, L.L. Selection and characterization of strains of Streptomyces suppressive to the potato scab pathogen. Can. J. Microbiol. 1996, 42, 487–502. [Google Scholar] [CrossRef]
- Ryan, A.D.; Kinkel, L.L. Inoculum density and population dynamics of suppressive and pathogenic Streptomyces strains and their relationship to biological control of potato scab. Biol. Control 1997, 10, 180–186. [Google Scholar] [CrossRef]
- Zarandi, M.E.; Bonjar, G.S.; Dehkaei, F.P.; Moosavi, S.A.; Farokhi, P.R.; Aghighi, S. Biological control of rice blast (Magnaporthe oryzae) by use of Streptomyces sindeneusis isolate 263 in greenhouse. Am. J. Appl. Sci. 2009, 6, 194–199. [Google Scholar] [CrossRef]
- Bubici, G.; Marsico, A.D.; D’Amic, M.; Ameduni, M.; Cirulli, M. Evaluation of Streptomyces spp. for the biological control of corky root of tomato and Verticillium wilt of eggplant. Appl. Soil Ecol. 2013, 72, 128–134. [Google Scholar] [CrossRef]
- Sunpapao, A.; Chairin, T.; Ito, S. The biocontrol by Streptomyces and Trichoderma of leaf spot disease caused by Curvularia oryzae in oil palm seedlings. Biol. Control 2018, 123, 36–42. [Google Scholar] [CrossRef]
- Wonglom, P.; Suwannarach, N.; Lumyong, S.; Ito, S.; Matsui, K.; Sunpapao, A. Streptomyces angustmyceticus NR8-2 as a potential microorganism for the biological control of leaf spots of Brassica rapa subsp. pekinensis caused by Colletotrichum sp. and Curvularia lunata. Biol. Control 2019, 138, 104406. [Google Scholar] [CrossRef]
- Yu, Z.; Han, C.; Yu, B.; Zhao, J.; Yan, Y.; Huang, S.; Liu, C.; Xiang, W. Taxonomic characterization, and secondary metabolite analysis of Streptomyces triticiradicis sp. nov.: A novel actinomycete with antifungal activity. Microorganisms 2020, 8, 77. [Google Scholar] [CrossRef]
- Zhuang, X.; Gao, C.; Peng, C.; Wang, Z.; Zhao, J.; Shen, Y.; Liu, C. Characterization of a novel endophytic actinomycete, Streptomyces physcomitrii sp. nov., and its biocontrol potential against Ralstonia solanacearum on tomato. Microorganisms 2020, 8, 2025. [Google Scholar] [CrossRef] [PubMed]
- Conn, V.M.; Walker, A.R.; Franco, C.M. Endophytic actinobacteria induce defense pathways in Arabidopsis thaliana. Mol. Plant Microbe Interact. 2008, 21, 208–218. [Google Scholar] [CrossRef] [PubMed]
- Kurth, F.; Mailander, S.; Bonn, M.; Feldhahn, L.; Herrmann, S.; Grosse, I.; Buscot, F.; Schrey, S.D.; Tarkka, M.T. Streptomyces-induced resistance against oak powdery mildew involves host plant responses in defense, photosynthesis, and secondary metabolism pathways. Mol. Plant Microbe Interact. 2014, 27, 891–900. [Google Scholar] [CrossRef]
- Chen, J.; Hu, L.; Chen, N.; Jia, R.; Ma, Q.; Wang, Y. The biocontrol and plant growth-promoting properties of Streptomyces alfalfae XN-04 revealed by functional and genomic analysis. Front. Microbiol. 2021, 12, 745766. [Google Scholar] [CrossRef]
- Wang, Z.; Solanki, M.K.; Yu, Z.-X.; Anas, M.; Dong, D.-F.; Xing, Y.-X.; Malviya, M.K.; Pang, F.; Li, Y.-R. Genome characteristics reveal the biocontrol potential of actinobacteria isolated from sugarcane rhizosphere. Front. Microbiol. 2021, 12, 797889. [Google Scholar] [CrossRef] [PubMed]
- Qi, D.; Zou, L.; Zhou, D.; Zhang, M.; Wei, Y.; Li, K.; Zhao, Y.; Zhang, L.; Xie, J. Biocontrol potential and antifungal mechanism of a novel Streptomyces sichuanensis against Fusarium oxysporum f. sp. cubense tropical race 4 in vitro and in vivo. Appl. Microbiol. Biotechnol. 2022, 106, 1633–1649. [Google Scholar] [CrossRef]
- Díaz-Díaz, M.; Bernal-Cabrera, A.; Trapero, A.; Medina-Marrero, R.; Sifontes-Rodríguez, S.; Cupull-Santana, R.D.; García-Bernal, M.; Agustí-Brisach, C. Characterization of actinobacterial strains as potential biocontrol agents against Macrophomina phaseolina and Rhizoctonia solani, the main soil-borne pathogens of Phaseolus vulgaris in Cuba. Plants 2022, 11, 645. [Google Scholar] [CrossRef]
- Le, K.D.; Yu, N.H.; Park, A.R.; Park, D.-J.; Kim, C.-J.; Kim, J.-C. Streptomyces sp. AN090126 as a biocontrol agent against bacterial and fungal plant diseases. Microorganisms 2022, 10, 791. [Google Scholar] [CrossRef]
- Nair, R.M.; Yang, R.Y.; Easdown, W.J.; Thavarajah, D.; Thavarajah, P.; Hughes, J.D.A.; Keatinge, J.D.H. Biofortification of mungbean (Vigna radiata) as a whole food to enhance human health. J. Sci. Food Agric. 2013, 93, 1805–1813. [Google Scholar] [CrossRef]
- Sun, S.; Sun, F.; Deng, D.; Zhu, X.; Duan, C.; Zhu, Z. First report of southern blight of mungbean caused by Sclerotium rolfsii in China. Crop Protec. 2020, 130, 105055. [Google Scholar] [CrossRef]
- Bulluck, L.R.; Ristaino, J.B. Effect of synthetic and organic soil fertility amendments on southern blight, soil microbial communities. Phytopathology 2002, 92, 181–189. [Google Scholar] [CrossRef] [PubMed]
- Culbreath, A.K.; Brenneman, T.B.; Kemerait, R.C. Effect of the new pyrazole carboxamide fungicide penthiopyrad on late leaf spot and stem rot of peanut. Pest Manag. Sci. 2009, 65, 66–73. [Google Scholar] [CrossRef] [PubMed]
- Yoon, M.Y.; Cha, B.; Kim, J.C. Recent trends in studies on botanical fungicides in agriculture. Plant Pathol. J. 2013, 29, 1–9. [Google Scholar] [CrossRef] [PubMed]
- Fattahi, E.; Mousavi Moghadam, M.; Khanbabaei, R. The effect of fricyclazole on testosterone changes and testicular structure in mice. J. Babol. Univ. Med. Sci. 2015, 17, 43–49. [Google Scholar]
- Sajid, I.; Shaaban, K.A.; Hasnain, S. Identification, isolation and optimization of antifungal metabolites from the Streptomyces alachitofuscus ctf9. Braz. J. Microbiol. 2011, 42, 592–604. [Google Scholar] [CrossRef]
- Fróes, A.; Macrae, A.; Rosa, J.; Franco, M.; Souza, R.; Soares, R.; Coelho, R. Selection of a Streptomyces strain able to produce cell wall degrading enzymes and active against Sclerotinia sclerotiorum. J. Microbiol. 2012, 50, 798–806. [Google Scholar] [CrossRef]
- Lee, S.Y.; Tindwa, H.; Lee, Y.S.; Naing, K.W.; Hong, S.H.; Nam, Y.; Kim, K.Y. Biocontrol of anthracnose in pepper using chitinase, beta-1,3 glucanase, and 2-furancarboxaldehyde produced by Streptomyces cavourensis SY224. J. Microbiol. Biotechnol. 2012, 22, 1359–1366. [Google Scholar] [CrossRef]
- Wang, C.; Wang, Z.; Qiao, X.; Li, Z.; Li, F.; Chen, M.; Wang, Y.; Huang, Y.; Cui, H. Antifungal activity of volatile organic compounds from Streptomyces alboflavus TD-1. FEMS Microbiol. Lett. 2013, 341, 45–51. [Google Scholar] [CrossRef]
- Ayed, A.; Kalai-Grami, L.; Slimene, I.B.; Chaouachi, M.; Mankai, H.; Karkouch, I.; Djebali, N.; Elkahoui, S.; Tabbene, O.; Limam, F. Antifungal activity of volatile organic compounds from Streptomyces sp. strain S97 against Botrytis cinerea. Biocontrol Sci. Technol. 2021, 31, 1330–1348. [Google Scholar] [CrossRef]
- Droby, S.; Wisniewski, N.; Benkeblia, N. Postharvest pathology of tropical and subtropical fruit and strategies for decay control. In Postharvest Biology and Technology of Tropical and Subtropical Fruits; Yahia, E.M., Ed.; Woodhead Publishing: Cambridge, UK, 2011; pp. 194–223. [Google Scholar]
- Zhang, H.; Chen, L.; Sun, Y.; Zhao, L.; Zhen, X.; Yang, Q.; Zhang, X. Investigating proteome and transcriptome defense response of apples induced by Yarrowia lipolytica. Mol. Plnat Microbe Interact. 2017, 30, 301–311. [Google Scholar] [CrossRef]
- Yang, Q.; Wang, H.; Zhang, H.; Zhang, X.; Apaliya, M.T.; Zheng, X.; Mahunu, G.K. Effect of Yarrowia lipolytica on postharvest decay of grapes caused by Talaromyces regulosus and the protein expression profile of the T. regulosus. Postharvest Biol. Technol. 2017, 126, 15–22. [Google Scholar] [CrossRef]
- Islam, M.J.; Amin, M.R.; Ahmed, M.F.; Khatun, S.; Rahman, M.L.; Siddiqui, S.A.; Rahman, M.A.; Kudrat-E-Zahan, M.; Mannan, M.A. In-Vitro antimicrobial activity of essential oils and different organic extracts of Lippia alba. J. Phytochem. Biochem. 2018, 2, 1000107. [Google Scholar]
- Lin, G.S.; Duan, W.G.; Yang, L.X.; Huang, M.; Lei, F.H. Synthesis and antifungal activity of novel myrtenal based 4-methyl-1,2,4-triazole-thioethers. Molecules 2017, 22, 193. [Google Scholar] [CrossRef]
- Lin, G.; Chen, Z.; Duan, W.; Wang, X.; Lei, F. Synthesis and biological activity of novel myrtenal-derived 2-acyl-1,2,4-triazole-3-thione compounds. Chin. J. Org. Chem. 2018, 38, 2085–2092. [Google Scholar] [CrossRef]
- Wu, Y.; Yuan, J.; Yaoyao, E.; Raza, W.; Shen, Q.; Huang, Q. Effects of volatile organic compounds from Streptomyces albulus NJZJSA2 on growth of two fungal pathogens. J. Basic Microbiol. 2015, 55, 1104–1117. [Google Scholar] [CrossRef] [PubMed]
- Jung, S.J.; Kim, N.K.; Lee, D.-H.; Hong, S.I.; Lee, J.K. Screening and evaluation of Streptomyces species as a potential biocontrol agent against a wood decay fungus, Gloeophyllum trabeum. Mycobiology 2018, 46, 138–146. [Google Scholar] [CrossRef] [PubMed]
- Chaiharn, M.; Theantana, T.; Pathom-aree, W. Evaluation of biocontrol activities of Streptomyces spp. against rice blast disease fungi. Pathogens 2020, 9, 126. [Google Scholar] [CrossRef] [PubMed]
- Yang, M.; Wei, Q.; Shi, L.; Wei, Z.; Lv, Z.; Asim, N.; Zhang, K.; Ge, B. Wuyiencin produced by Streptomyces albulus CK-15 displays biocontrol activities against cucumber powdery mildew. J. Appl. Microbiol. 2021, 131, 2957–2970. [Google Scholar] [CrossRef]
- Pithakkit, S.; Petcharat, V.; Chuenchit, S.; Pornsuriya, C.; Sunpapao, A. Isolation of actinomycetes species from rhizosphere as effective biocontrol against oil palm fungal diseases. Walailak J. Sci. Technol. 2015, 12, 481–490. [Google Scholar]
- Ruangwong, O.-U.; Kunasakdakul, K.; Daengsuwan, W.; Wonglom, P.; Pitija, K.; Sunpapao, A. A Streptomyces rhizobacterium with antifungal properties against spadix rot in flamingo flowers. Physiol. Molec. Plant Pathol. 2022, 117, 101784. [Google Scholar] [CrossRef]
- Rahman, M.A.; Begum, M.F.; Alam, M.F. Screening of Trichoderma isolates as a biological control agent against Ceratocystis paradoxa causing pineapple disease of sugarcane. Microbiology 2009, 37, 277–285. [Google Scholar]
- Miller, G.L. Use of dinitrosalicylic acid reagent for determination of reducing sugar. Anal. Biochem. 1959, 31, 426–428. [Google Scholar] [CrossRef]
- Phoka, N.; Suwannarach, N.; Lumyong, S.; Ito, S.; Matsui, K.; Arikit, S.; Sunpapao, A. Role of volatiles from the endophytic fungus Trichoderma asperelloides PSU-P1 in biocontrol potential and in promoting the plant growth of Arabidopsis thaliana. J. Fungi 2020, 6, 341. [Google Scholar] [CrossRef] [PubMed]
- Intana, W.; Kheawleng, S.; Sunpapao, A. Trichoderma asperellum T76-14 released volatile organic compounds against postharvest fruit rot in muskmelons (Cucumis melo) caused by Fusarium incarnatum. J. Fungi 2021, 7, 46. [Google Scholar] [CrossRef]
- Ruangwong, O.-U.; Wonglom, P.; Suwannarach, N.; Kumla, J.; Thaochan, N.; Chomnunti, P.; Pitija, K.; Sunpapao, A. Volatile organic compound from Trichoderma asperelloides TSU1: Impact on plant pathogenic fungi. J. Fungi 2021, 7, 187. [Google Scholar] [CrossRef] [PubMed]
- Ruangwong, O.-U.; Pornsuriya, C.; Pitija, K.; Sunpapao, A. Biocontrol mechanisms of Trichoderma koningiopsis PSU3-2 against postharvest anthracnose of chili pepper. J. Fungi 2021, 7, 276. [Google Scholar] [CrossRef]
- Chiang, K.S.; Liu, H.I.; Bock, C.H. A discussion on disease severity index values. Part I: Warning on inherent errors and suggestions to maximise accuracy. Ann. Appl. Biol. 2017, 171, 139–154. [Google Scholar] [CrossRef]
- Reddy, N.G.; Ramakrishna, D.P.N.; Raja, S.V. A morphological, physiological and biochemical studies of marine Streptomyces rochei (MTCC 10109) showing antagonistic activity against selective human pathogenic microorganisms. Asian J. Biol. Sci. 2011, 4, 1–14. [Google Scholar] [CrossRef][Green Version]
- Kumar, S.; Stecher, G.; Li, M.; Knyaz, C.; Tamaru, K. MEGA X: Molecular evolutionary genetics analysis across computing platforms. Mol. Biol. Evol. 2018, 35, 1547–1549. [Google Scholar] [CrossRef]

| RT (min) | Compounds | %Match | Formula | MW | Peak Area |
|---|---|---|---|---|---|
| 6.41 | 2,6-Dimethyl-1,3,6-heptatriene | 89 | C9H14 | 122 | 76,249 |
| 6.80 | (1R)-(-)-Myrtenal | 87 | C10H14O | 150 | 44,937 |
| 11.02 | 3,3-dimethyl-6-methylenecyclohexene | 86 | C9H14 | 122 | 36,671 |
| 11.17 | 7-propylidene-bicyclo[4.1.0]heptane | 89 | C10H16 | 136 | 23,318 |
Publisher’s Note: MDPI stays neutral with regard to jurisdictional claims in published maps and institutional affiliations. |
© 2022 by the authors. Licensee MDPI, Basel, Switzerland. This article is an open access article distributed under the terms and conditions of the Creative Commons Attribution (CC BY) license (https://creativecommons.org/licenses/by/4.0/).
Share and Cite
Ruangwong, O.-U.; Kunasakdakul, K.; Chankaew, S.; Pitija, K.; Sunpapao, A. A Rhizobacterium, Streptomyces albulus Z1-04-02, Displays Antifungal Activity against Sclerotium Rot in Mungbean. Plants 2022, 11, 2607. https://doi.org/10.3390/plants11192607
Ruangwong O-U, Kunasakdakul K, Chankaew S, Pitija K, Sunpapao A. A Rhizobacterium, Streptomyces albulus Z1-04-02, Displays Antifungal Activity against Sclerotium Rot in Mungbean. Plants. 2022; 11(19):2607. https://doi.org/10.3390/plants11192607
Chicago/Turabian StyleRuangwong, On-Uma, Kaewalin Kunasakdakul, Sompong Chankaew, Kitsada Pitija, and Anurag Sunpapao. 2022. "A Rhizobacterium, Streptomyces albulus Z1-04-02, Displays Antifungal Activity against Sclerotium Rot in Mungbean" Plants 11, no. 19: 2607. https://doi.org/10.3390/plants11192607
APA StyleRuangwong, O.-U., Kunasakdakul, K., Chankaew, S., Pitija, K., & Sunpapao, A. (2022). A Rhizobacterium, Streptomyces albulus Z1-04-02, Displays Antifungal Activity against Sclerotium Rot in Mungbean. Plants, 11(19), 2607. https://doi.org/10.3390/plants11192607

